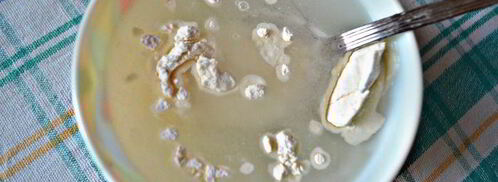
тефтели с грибами в томатном соусе. Шаг 7

Тефтели с грибами в томатном соусе
От: Серафима Трощилова

Фото тефтелей с грибами в томатнома соусе.
Похожие рецепты
Предлагаю вам приготовить очень вкусное, сытное и уютное блюдо для семейного обеда или ужина. Любите готовить тефтели? Попробуйте рецепт мясных тефтелей в томатнома соусе. Должно понравиться.
- Рецепт: Простой
- Время приготовления: 1 ч 30 мин
- Порций: 6
- Калорий: 242 ккал
- Кухня: Домашняя
Ингредиенты
- шампиньоны - 250 г
- сыр - 50 г
- лук репчатый - 1 шт.
- чеснок - 1 зубчик
- рис - ½ стак.
- томатный сок - 1 стак.
- мука - 2 ст.л.
- сметана 20% - 3 ст.л.
- растительное масло - 1 ст.л.
- соль - по вкусу
- сахар - 1 ч.л.
- перец черный свежемолотый - по вкусу
- укроп свежий - 3 веточки
- мясной фарш - 300 г
Как приготовить тефтели с грибами в томатнома соусе дома
-
Нам понадобится 0,5 ст (100г) отварного риса.
-
Подготовьте мясной фарш (у меня свинина + говядина).

-
Измельчите лук, очистите и порежьте грибы, с помощью пресса измельчите чеснок.

-
Сыр твердых сортов (у меня - Джугас) натрите на мелкой терке, укроп мелко порубите. К фаршу добавьте рис, лук с чесноком, грибы, укроп, посолите и поперчите по вкусу.

-
Все хорошо вымешайте. Руки смочите холодной водой и сформируйте из полученного фарша тефтели. Форму для запекания смажьте растительным маслом и выложите в нее тефтели.

-
Для соуса к томатному соку добавьте сахар, сметану и перемешайте, а при необходимости - подсолите.

-
Муку перемешайте с 0,5 стакана холодной воды и хорошо размешайте, чтобы не было комочков. Затем соедините с томатно-сметанной смесью.

-
Тефтели залейте получившимся соусом. Форму с тефтелями накройте фольгой и запекайте в разогретой до 180г духовке в течение 50 мин - 1ч.

-
Готовые тефтели подавайте со спагетти или картофелем, полив обильно томатным соусом и посыпав рубленной зеленью. Приятного вам аппетита!

На заметку
Главное не опускать руки, тогда всё получится. Рекомендую тефтели с моцареллой в томатнома соусе. Должно быть вкусно. Чаще готовьте новые блюда, нужно быть в форме! Всегда стараюсь приготовить что-нибудь новое.

Комментарии к рецепту
Спасибо за шедевры, спасибо что вы делайте для нас
успехов вам! счастья, любви, здоровья.
Спасибо!
тефтели с грибами в томатном соусе теперь моё коронное блюдо, никого не оставляет равнодушным…;)))
Я тоже обожаю тефтели с грибами в томатном соусе
но сама делала только один раз.
Спасибо, Серафима, очень обстоятельно, красиво, захотелось сделать, ну скажем завтра!
А уж про ближайший праздник и говорить нечего!
Как просто и вкусно, да еще и красиво. А вот в тему мясные тефтели в сметанно-томатном соусе recipetoday.ru/goryachee/tefteli/myasnye-tefteli-v-smetanno-tomatnom-souse.
Обалденный!
сегодня или завтра повторю.
Приготовила на ДР Любимого.
Немного переживала, что что-нибудь будет не так
все переживания были напрасны!
всем понравилось!